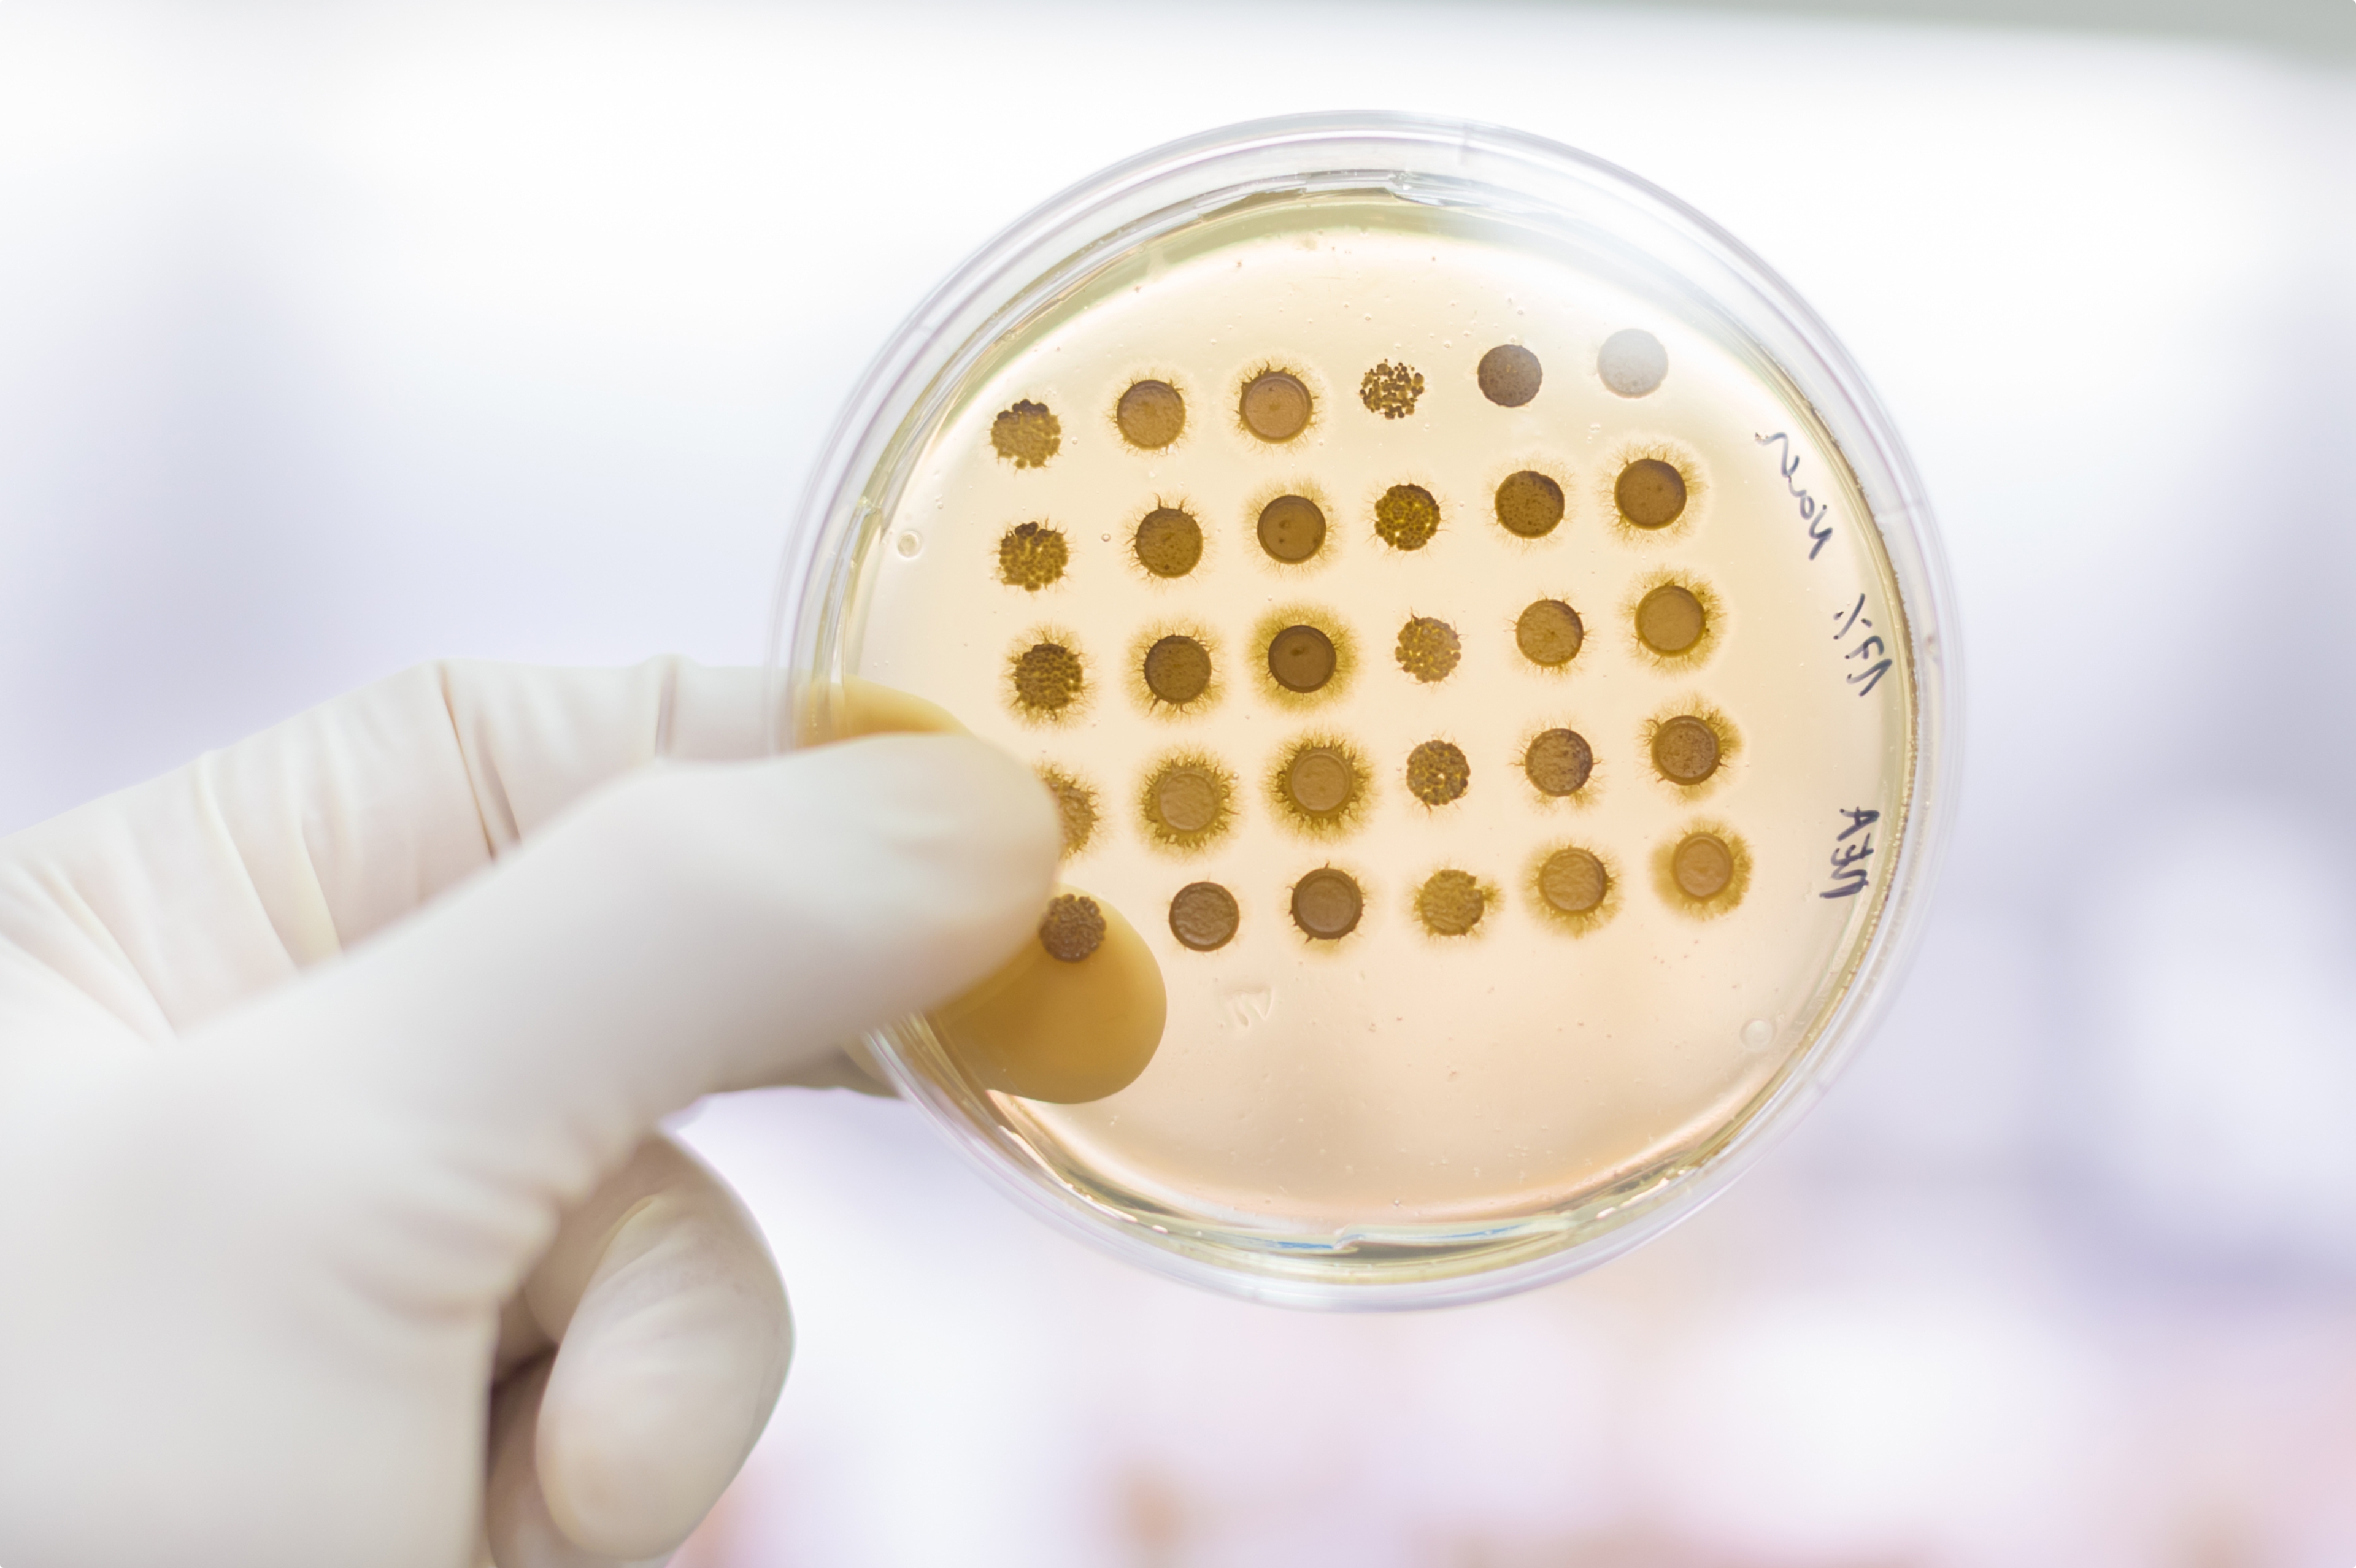

CAMBRIDGE, Mass.—(PR NEWSWIRE)—Concerto Biosciences, a biotechnology company that leverages a powerful screening technology called kChip to rapidly discover microbial, prebiotic, and postbiotic product candidates, today announced the first participant has been dosed in their Phase 1, first-in-human trial of ENS-002, a three-strain live biotherapeutic product being developed to address atopic dermatitis by targeting Staphylococcus aureus (S. aureus), a key driver of skin inflammation.
“We are thrilled to have our first participant enrolled,” said Chief Executive Officer Cheri Ackerman. “For the millions of people who suffer from atopic dermatitis (AD), or eczema, ENS-002 represents a potential paradigm shift in care.” Current treatments like steroids and immunosuppressants may come with side effects or diminishing effectiveness over time; the AD pipeline remains dominated by drugs addressing similar immune-suppressing mechanisms of action. ENS-002 is unique in its approach: Concerto hypothesizes that by addressing a microbiome deficiency underlying atopic dermatitis, ENS-002 can offer a novel route to longer-lasting relief and fewer side effects.
ENS-002 was discovered with kChip, which screens millions of microbial combinations to generate the world’s largest dataset on how microbes interact, compete, and cooperate under diverse conditions. These data allow for precise, predictive insights into microbial behavior and function that lead to the discovery of products like ENS-002.
“This clinical milestone marks a promising step forward not only in managing a challenging skin condition but also in demonstrating the potential of precisely selected microbial combinations to address complex diseases rooted in microbiome deficiencies,” said Ackerman. “Demonstration of this therapeutic approach could change the way we think about the mechanisms and therapeutic possibilities in a wide variety of diseases.”
The ENS-002 clinical study is designed to enroll approximately nine participants across three cohorts of increasing dose concentration and dose frequency. Primary endpoints are safety and tolerability, and secondary endpoints are the ability of ENS-002 to control S. aureus abundance and address atopic dermatitis. Sites for the Phase 1 clinical trial of ENS-002, Topical ENS-002 for Atopic Dermatitis in Adults (EnSync), are now open for enrollment. For more information, visit clinicaltrials.gov (NCT06469385). Concerto anticipates being able to report safety and preliminary proof of mechanism data in 2025.
In partnership with a diverse array of biotech and biopharma companies, Concerto aims to unleash a new era of microbial research and a treasure trove of microbe-based products.
750 Main Street
Cambridge, MA 02139